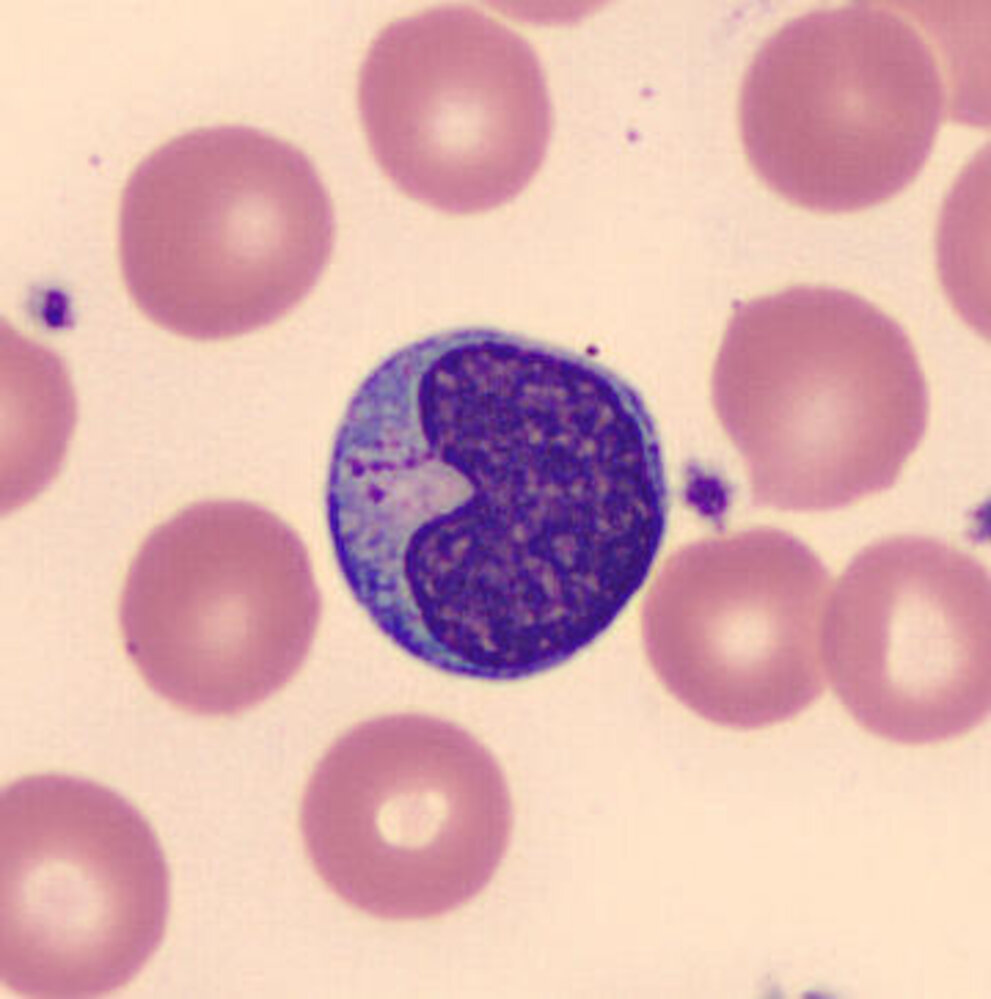
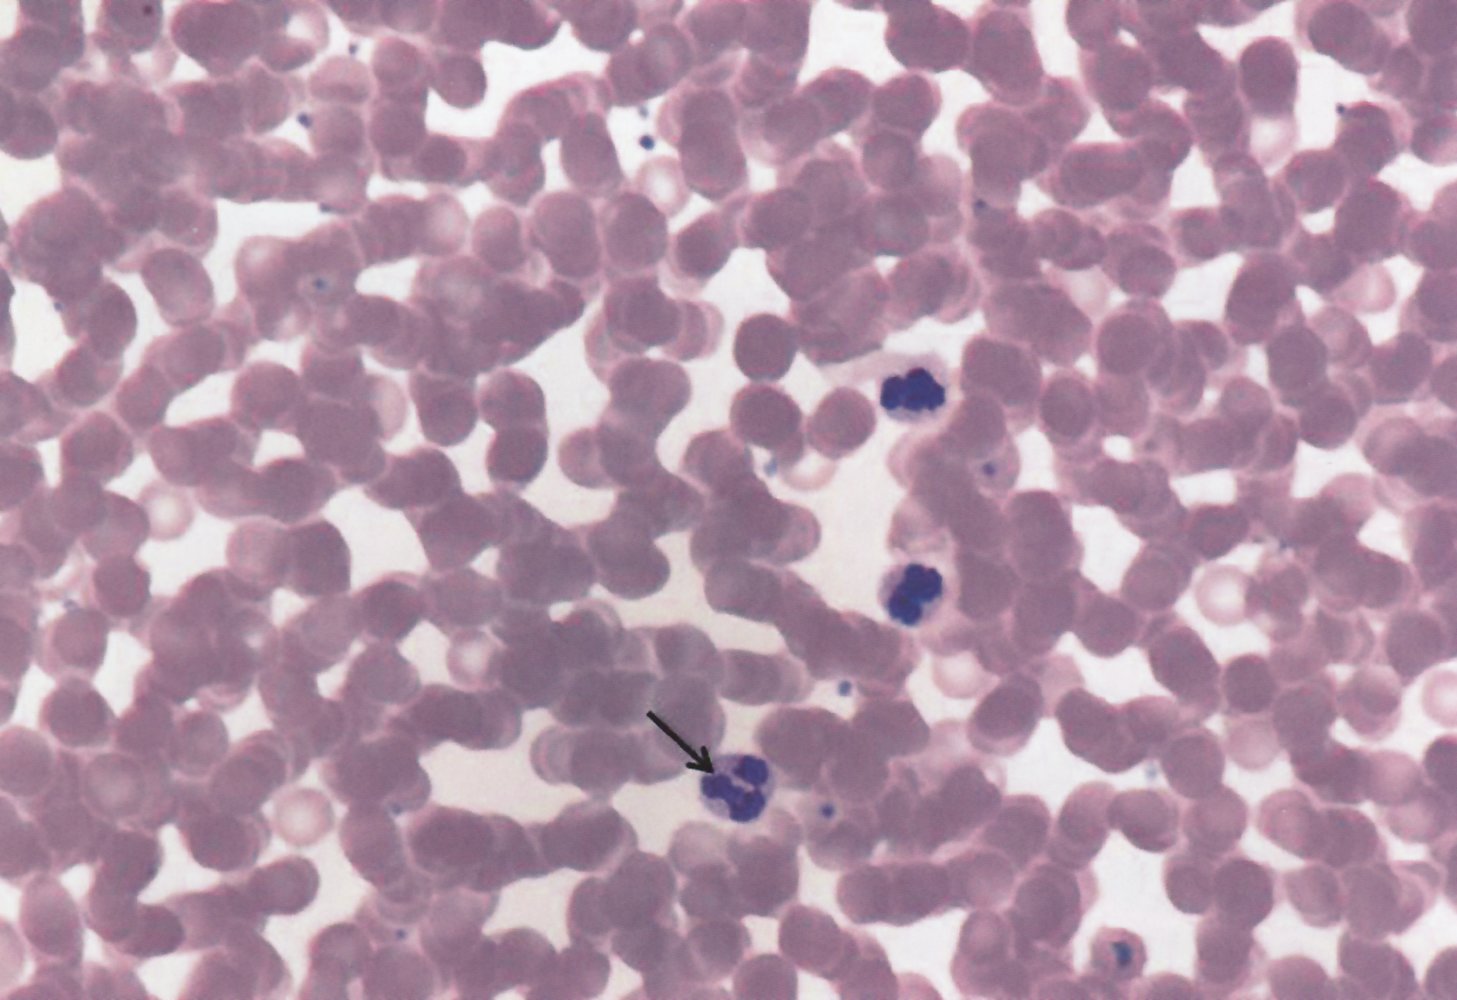
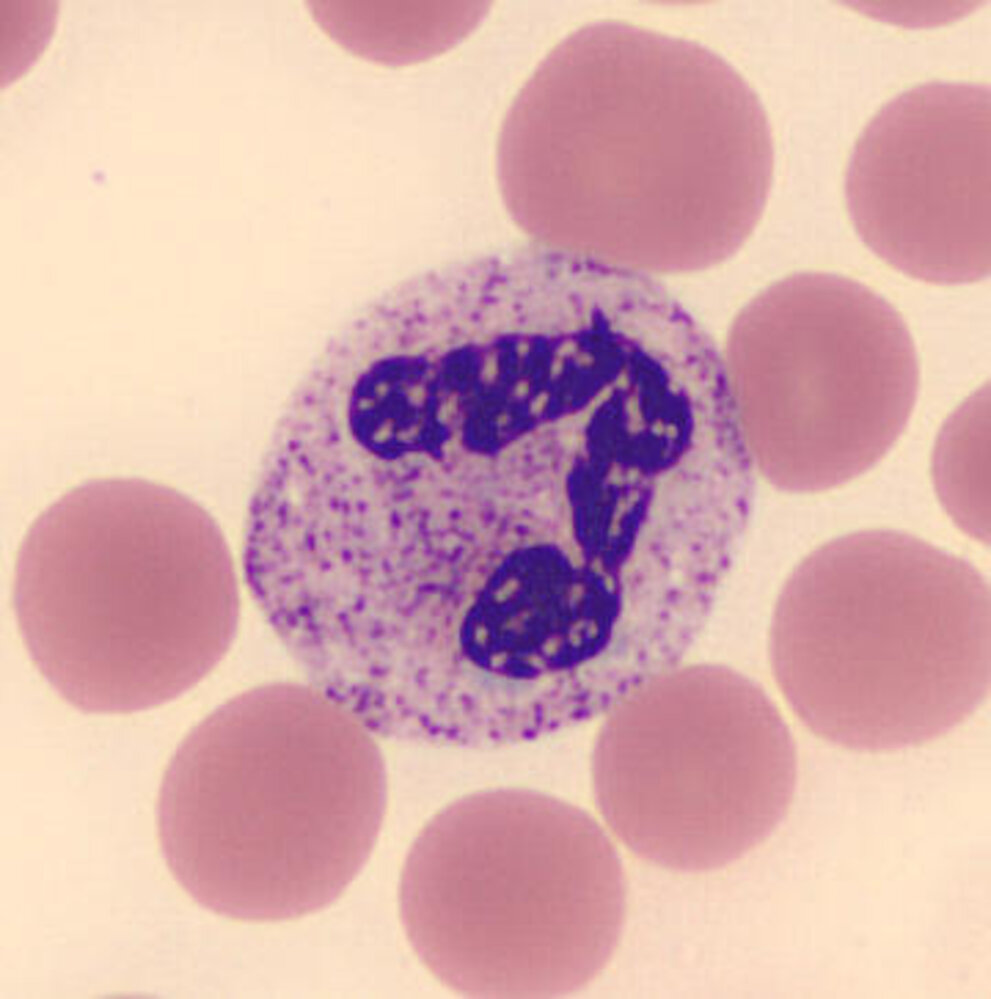
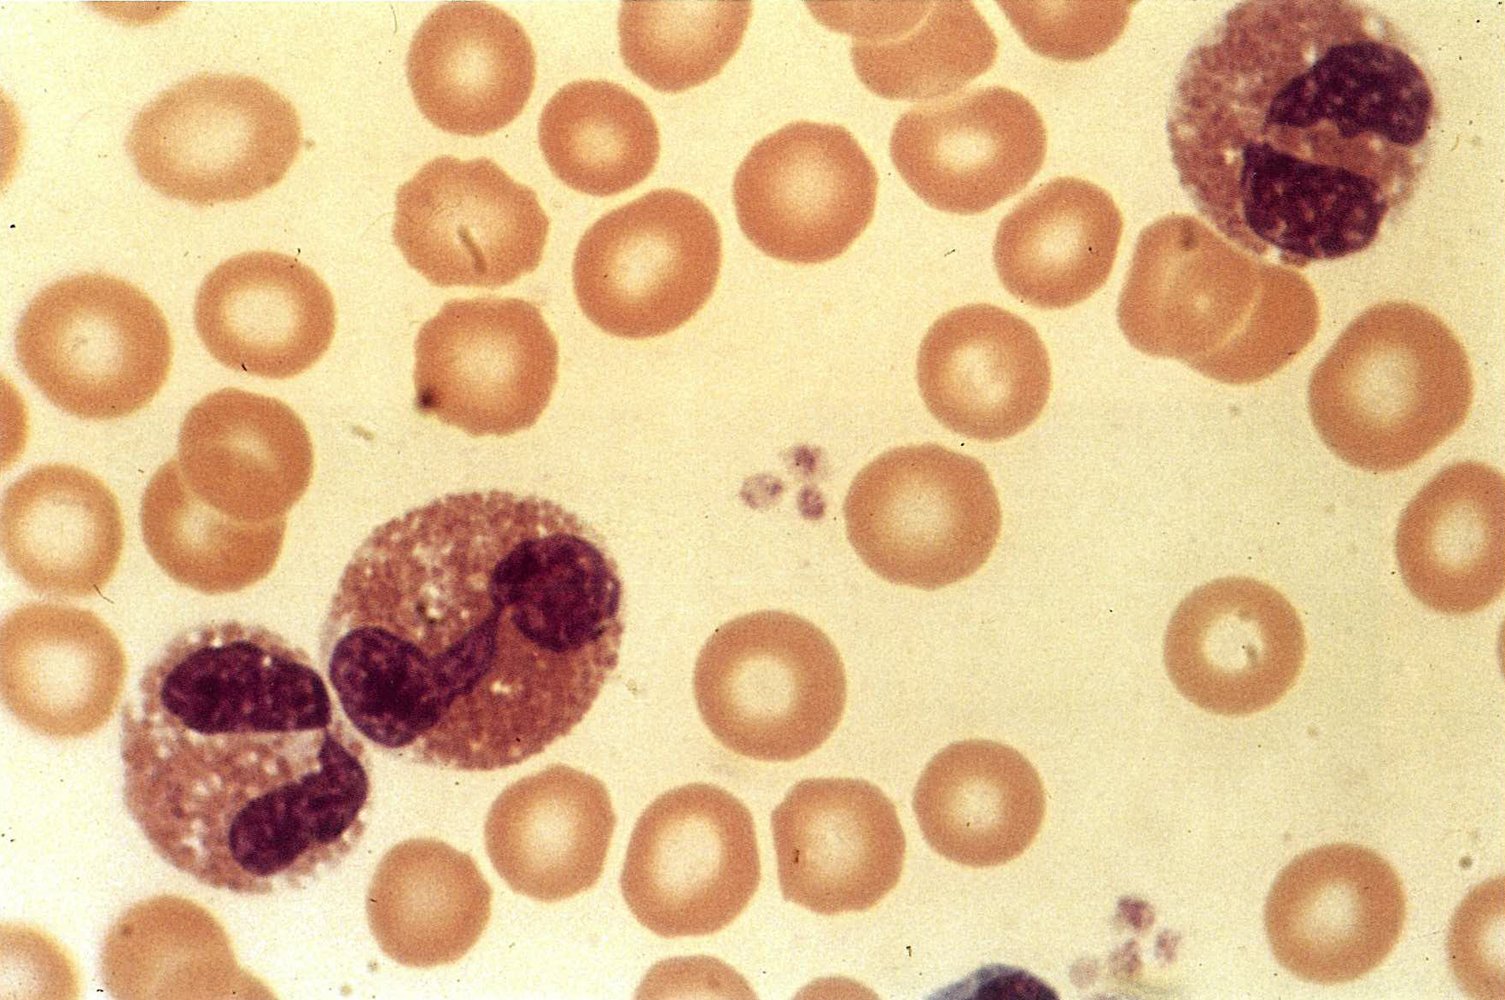
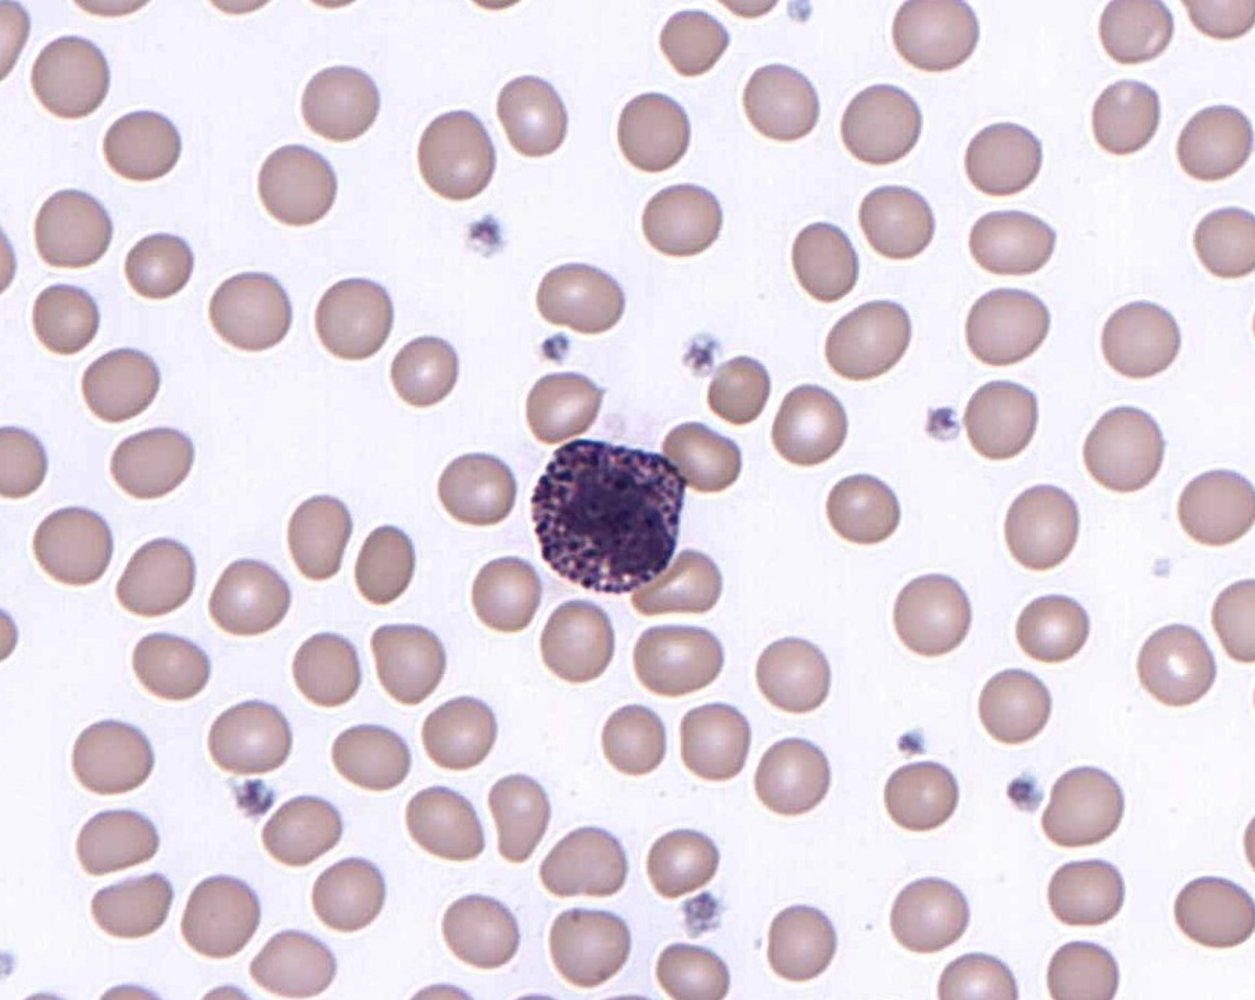
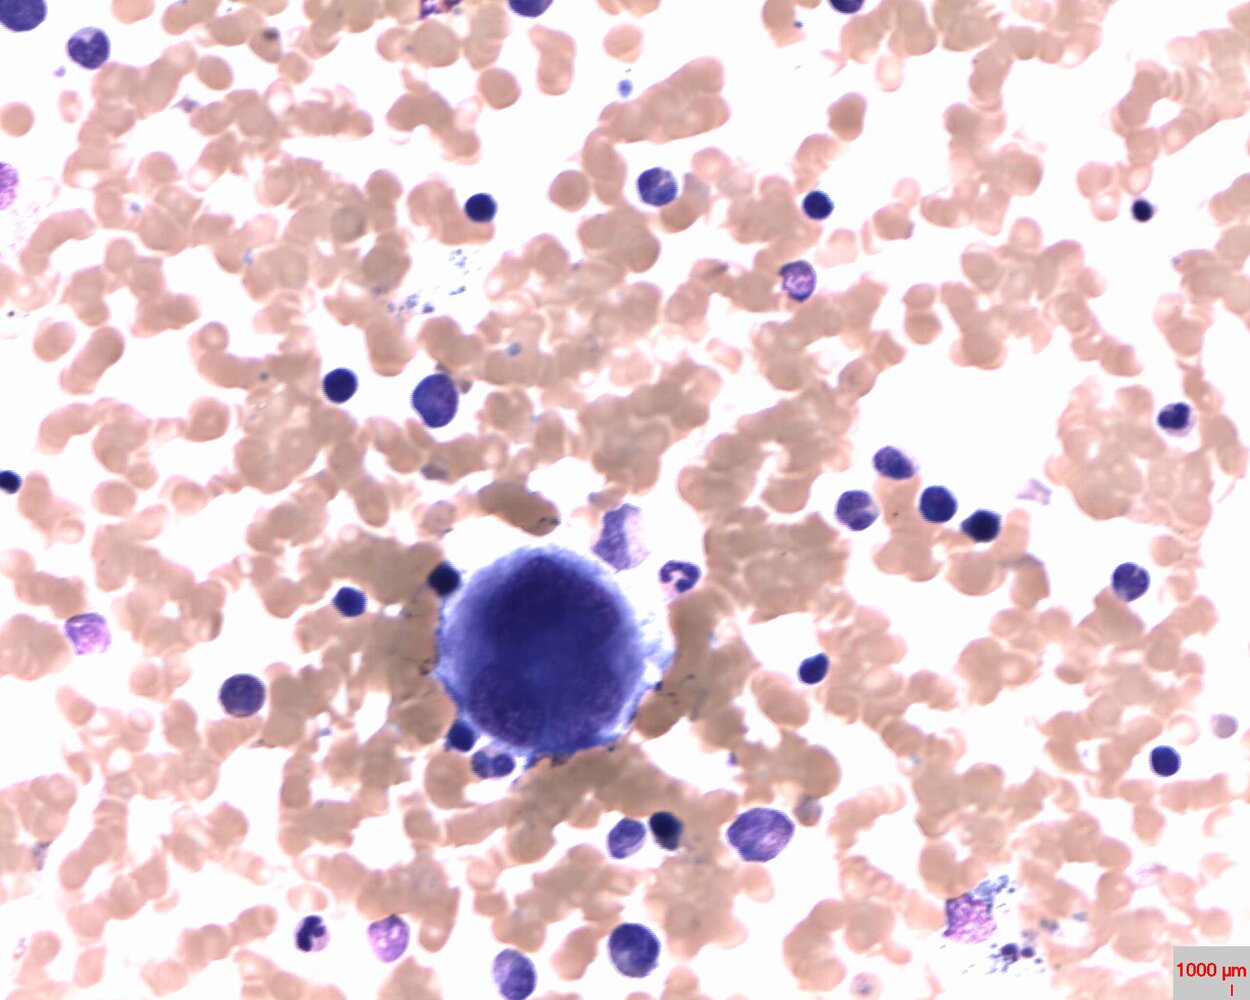

Hematology is the study of blood and the disorders related to it. Human blood consists of blood cells and plasma. Blood has many functions, including transporting oxygen and nutrients to tissues, removing waste materials (e.g., carbon dioxide, urea), regulating body temperature, and carrying cells responsible for coagulation and immune response. There are three main types of blood cells, all of which originate from hematopoietic stem cells, which are located primarily in the bone marrow: red blood cells (RBCs; erythrocytes), white blood cells (WBCs; leukocytes), and platelets (thrombocytes). RBCs are hemoglobin-carrying cells that primarily transport oxygen. There are two types of WBCs: granulocytes and lymphocytes. Granulocytes are part of the innate immune system and play a key role in the immune response to bacteria, fungi, and parasites. Lymphocytes include cells that are responsible for both the innate (natural killers) and adaptive (T and B cells) immune system. T and B cells, in contrast to the cells involved in innate immunity, can target specific antigens presented to them by antigen-presenting cells. Platelets, small anucleate cells produced by megakaryocytes, are required for hemostasis.
Functions of blood [1][2]
- Transport of:
- Oxygen, nutrients, and hormones to tissues
- Carbon dioxide to the lungs for elimination
- Metabolic waste products to kidneys and liver for elimination
- Protection from pathogens
- Hemostasis
- Regulation of body temperature, signal transmission, and acid-base homeostasis
Blood volume
- On average, blood constitutes ∼ 7% of the total body weight of adults (∼ 70 mL/kg). [1][3]
- The actual circulating blood volume varies and depends on age, weight, and height.
- For children ≥ 35 kg, adolescents, and adults, the total blood volume can be estimated using the Nadler equation: [4]
- Men: BV = (0.3669 × H3) + (0.03219 × W) + 0.6041
- Women: BV = (0.3561 × H3) + (0.03308 × W) + 0.1833
- BV: blood volume in liters
- H: height in meters
- W: weight in kilograms
- For neonates, infants, and children up to 14 years, the following estimates can be used: [5]
| Blood volume in individuals of different age | |
|---|---|
| Age | Estimated blood volume (mL/kg) |
| 0–30 days | 80–85 |
| 1–12 months | 75–80 |
| 13–24 months | 85 |
| 2–3 years | 80 |
| 4–6 years | 76–77 |
| 7–14 years | 70–75 |
Blood constituents [1][2][3]
-
Plasma: ∼ 55%
- The liquid constituent of blood
- Composed of water, plasma proteins (including coagulation factors), electrolytes, hormones, and other bioactive substances
- Blood cells: ∼ 45%
| Overview of blood cell types | ||||
|---|---|---|---|---|
| Cell | Characteristics | Function | ||
| RBC (erythrocyte) |
|
|
||
| WBC (leukocyte) | Neutrophil |
|
|
|
| Eosinophil |
|
|
||
| Basophil |
|
|
||
| Monocyte |
|
|
||
| Lymphocyte |
|
|
||
| Thrombocyte |
|
|
||
| Blood cells in peripheral tissue | ||||
| Macrophage |
|
|
||
| Mast cell |
|
|
||
| Dendritic cell |
|
|
||
| Plasma cell |
|
|
||
Never Let Monkeys Eat Bananas: Neutrophils > Lymphocytes > Monocytes > Eosinophils > Basophils.

Bone marrow [2][7]
-
Definition
- Spongy, soft tissue that fills the hollow spaces within the cancellous bone
- Contains hematopoietic stem cells and stromal cells
-
Function
- Hematopoiesis (main function of bone marrow)
- Filters aging RBCs
- Houses immune cells (e.g., plasma cells)
| Types of bone marrow | ||
|---|---|---|
| Characteristic | Red marrow | Yellow marrow |
| Location |
|
|
| Function |
|
|
| Composition |
|
|



Stromal cells of the bone marrow [2][7]
Cells of the stromal compartment of bone marrow are not hematopoietic themselves, but they play a critical role in maintaining and regulating hematopoiesis (e.g., by removing potentially harmful cells and substances).
-
Adventitial reticular cells
- Divide the bone marrow into islands of hematopoietic cells
- Accumulate fat: can transform red marrow into yellow marrow
-
Mesenchymal stem cells
- Pluripotent stem cells
- Can differentiate into macrophages, adipocytes, fibroblasts, osteoblasts, osteoclasts, chondrocytes, myocytes, or endothelial cells
- Secrete stimulating factors required for hematopoiesis
- Macrophages: : located around sinusoids, in the extravascular surface of the marrow
Hematopoiesis (blood cell production) [2]
-
Definition: Hematopoiesis is the process by which multipotent hematopoietic stem cells differentiate into either myeloid or lymphoid precursor cells and, eventually, into mature blood cells. ; [2]
- Myeloid precursor cells develop into erythrocytes, granulocytes, or megakaryocytes.
- Lymphoid precursor cells develop into lymphocytes or natural killer cells
- Hematopoietic stem and progenitor cells express the transmembrane protein CD34 (used as a marker to identify and enrich hematopoietic stem cells in bone marrow transplantation). [10]
- Dendritic cells may derive from myeloid or lymphoid precursors. [6]
-
Location
- Before birth: yolk sac, spleen, liver
-
After birth
- Bone marrow
- Potentially spleen and liver, e.g., in the case of severe chronic anemia and some hematological malignancies (e.g., Hodgkin lymphoma)

Growth factors for hematopoiesis [1][2]
- Hematopoietic growth factors influence the differentiation and maturation of blood cells in all stages of their development.
- Some interleukins (e.g, IL-3, IL-6) also act as hematopoietic growth factors. See “Cytokines and eicosanoids” for more information.
| Overview of hematopoietic growth factors | ||
|---|---|---|
| Growth factor | Produced by | Function |
| Stem cell factor(SCF) |
|
|
| Granulocyte-monocyte colony-stimulating factor (GM-CSF) |
|
|
| Granulocyte colony-stimulating factor (G-CSF) |
|
|
| Macrophage colony-stimulating factor (M-CSF) |
|
|
| Erythropoietin (EPO) |
|
|
| Thrombopoietin(TPO) |
|
|
RomiPLoSTIM STIMulates PLatelets. SarGRaMoSTIM STIMulates GRanulocytes and Monocytes.

Erythropoiesis (RBC production) [2]
-
Location
-
During embryogenesis/fetal development
- Week 3–8: yolk sac [12]
- Week 6–birth: liver [12]
- Week 10–28: spleen [13]
- After week 18: red bone marrow [14]
-
After birth: red bone marrow
- In children: diaphyses of long bones (e.g., femur, tibia)
- In adults: mainly plain bones (pelvis, cranium, vertebrae, sternum) and metaphyses of long bones [15]
-
During embryogenesis/fetal development
- Duration: approx. 1 week (production and maturation)
- Regulation: primarily EPO, along with other hematopoietic growth factors, including GM-CSF, stem cell factor, and IL-3
-
Stages
-
In bone marrow
- Hematopoietic stem cell (erythroid progenitor cell)
- Proerythroblast: large cells with basophiliccytoplasm and a large nucleus
- Erythroblast: smaller nucleus than proerythroblasts; no nucleoli
- Normoblast: increasingly acidophilic cytoplasm with a compact nucleus
- Reticulocyte: acidophilic cytoplasm with granules composed of cytoplasmicribosomal RNA (enabling reticulocytes to be stained with methylene blue)
-
In blood
-
Reticulocytes are released into the blood.
-
The peripheral reticulocyte count reflects erythropoietic activity.
- Increased reticulocytes indicate increased erythropoiesis (e.g., due to hemolysis).
- Decreased reticulocytes indicate decreased erythropoiesis (e.g., due to aplastic anemia).
-
The peripheral reticulocyte count reflects erythropoietic activity.
- After 1–2 days, reticulocytes mature into erythrocytes.
-
Reticulocytes are released into the blood.
-
In bone marrow


To recall the sequence of prenatal erythropoiesis sites, think Young Livers Synthesize Blood: Yolk sac, Liver, Spleen, Bone marrow.
RBC morphology and physiology
- For the information about the structure and function of RBCs, see “Erythrocyte morphology and hemoglobin.”
- For associated laboratory values, see “Hematological parameters” in “Laboratory medicine.”
-
Leukocytes are classified into two cell lines:
- Myeloid cell line: granulocytes, mast cells, and monocytes
- Lymphoid cell line: lymphocytes
- For more information on WBC count and its abnormalities, see “Hematological parameters” in “Laboratory medicine.”
Myelopoiesis [1][2]
- Definition: the process by which granulocytes, monocytes, and mast cells develop from myeloid precursor cells
- Location: bone marrow
- Duration: 6 days [16]
-
Stages of development
- Granulocytes (granulopoiesis) : pluripotent hemopoietic stem cell → common myeloid precursor cell → myeloblast → promyelocyte → eosinophilic, neutrophilic, or basophilic myelocyte → metamyelocyte → band cell → granulocyte (eosinophil/neutrophil/basophil)
- Monocytes: pluripotent hemopoietic stem cell → common myeloid precursor cell → myeloblast → monoblast → promonocyte → monocyte
- Mast cells: pluripotent hemopoietic stem cell → common myeloid precursor cell → mast cell


Granulocytes [1][2][17][18][19]
- Granulocytes make up the largest portion of WBCs: 1,500–8,500/mm3. [20]
- An increase (granulocytosis) or decrease (granulocytopenia; see “Agranulocytosis”) usually contributes the most to changes in the total WBC count (see “Leukocytosis” and “Leukopenia”).
- See also “Hematological parameters” in “Laboratory medicine.”
| Types of granulocytes | ||||
|---|---|---|---|---|
| Cell | Characteristics | Function | Causes of increase | Causes of decrease |
| Neutrophil granulocyte |
|
|
|
|
| Eosinophil granulocyte |
|
|
|
|
| Basophil granulocyte |
|
|
|
|

Monocytes, macrophages, and mast cells [1][2][21]][22]
| Characteristics of tissue-residing immune cells | ||||
|---|---|---|---|---|
| Cell type | Characteristics | Function | Causes of increase | Causes of decrease |
| Monocyte |
|
|
|
|
| Macrophage |
|
|
|
|
| Mast cell [24] |
|
|
|
|
Lymphopoiesis (lymphocyte production) [2][25]
- Stages of development: pluripotent hematopoietic stem cell → lymphoid progenitor cell → T cell, B cell, or NK cell
-
Location of lymphopoiesis: initially in the bone marrow
- The location of maturation depends on the cell type.
- T cells mature in the thymus. See “T cell development.”
- B cells mature in the bone marrow.
- Mature lymphocytes migrate to secondary lymphoid organs (e.g., lymph nodes).
- The location of maturation depends on the cell type.
-
Lymphocyte maturation
-
During the lymphocyte lifecycle, several mechanisms ensure that T and B cells respond to a large variety of foreign antigens, while not reacting to self-antigens.
- Somatic recombination: Random recombination of gene segments coding for lymphocyte receptors enables a cell to specialize in responding to a specific antigen.
- Central tolerance: apoptosis induced in autoreactive cells (respond to self-antigens)
- Mature lymphocytes circulate through the bloodstream, migrate into tissue, and return to the blood via lymphatic vessels.
- Peripheral tolerance: Mature cells that respond to self-antigens become anergic (lose their function) or undergo apoptosis.
- For more detailed information about T- and B-cell maturation and selection, see “Adaptive immune system.”
-
During the lymphocyte lifecycle, several mechanisms ensure that T and B cells respond to a large variety of foreign antigens, while not reacting to self-antigens.
Lymphocyte physiology
-
Concentration (blood)
- Reference range: 1,000–4,000/mm3 or 25%–33% of total leukocytes [19]
- For causes of increase and decrease, see “Lymphocytosis” and “Lymphopenia.”
-
Function
- Humoral immune response (B cells)
- Cell-mediated immune response (T cells, natural killer cells)
- Immunological memory
- See “Adaptive immune system” for more information.
T lymphocytes (T cells)
- Function: part of the acquired immune system; see “Adaptive immune system”
-
Surface markers
- All mature T cells express specific surface proteins that distinguish them from other lymphocytes and allow them to recognize antigens presented by MHC molecules of antigen-presenting cells.
- General T-cell markers: CD3, CD28, TCR
- The difference in surface protein expression (e.g., CD4 vs. CD8) determines the specific function of T-cell subtypes.
- Subtypes: T cells can be largely divided into CD8+ T cells (cytotoxic T cells) and CD4+ T cells (T helper cell subpopulations). See “T-cell subtypes.”
CD4/CD8 ratio
- Definition: CD4+ T cell levels divided by CD8+ T cell levels
-
Interpretation
-
↑ CD4/CD8 ratio associated with:
- Sarcoidosis
- Crohn disease
- Some vasculitides and collagenases (e.g., granulomatosis with polyangiitis)
-
↓ CD4/CD8 ratio associated with:
- HIV
- Extrinsic allergic alveolitis
-
↑ CD4/CD8 ratio associated with:

Natural killer T cells (NKT cells) [26]
-
Features
- Subtype of T cells
- Share characteristics of NK cells and T cells
- Have T-cell receptors
-
Function
- Produce large amounts of immunomodulatory cytokines during infection or inflammation → modulate immune response
- Recognize glycolipids presented via CD1d
B lymphocytes (B cells)
- Function: part of the acquired immune system (esp. antibody production); see “Adaptive immune system”
-
Surface markers include:
- CD20
- B-cell receptor (BCR)
-
Subtypes
- Plasma cells: After activation, B cells differentiate into plasma cells, which produce and secrete antibodies.
- Memory B cells: specialized plasma cells that provide a fast and specific immune response to reexposure to antigens
Natural killer cells (NK cells) [2][27][28]
-
Function
- Part of the innate immune system [29]
-
Detection and destruction of:
- Tumor cells
- Cells infected with viruses (esp. HHV family)
-
Physiology
- Can arise from both lymphoid and myeloid precursor cells [29]
-
Surface markers
-
Fc receptor (CD16): a membrane receptor protein that recognizes and binds to antibodies that have attached to pathogens
- Mediates a phagocytic and/or cytotoxic response
- Found on many immune cells, e.g., NK cells, neutrophils, and macrophages
- CD56: a neural cell adhesion molecule specific to NK cells
-
Fc receptor (CD16): a membrane receptor protein that recognizes and binds to antibodies that have attached to pathogens
- Produce IFN-γ and TNF-α (proinflammatory cytokines that recruit macrophages and promote phagocytosis)
- Stimulated by IFN-α, IFN‑β, IL-2, and IL-12
-
Mechanism of action
-
NK cells are activated under the following conditions:
- Nonspecific activation by a signal from a hostile cell (e.g., lipid antigens that are copresented with CD1 molecule)
- Absence of MHC Ireceptors on the hostile cell (e.g., virally infected cells that do not express MHC I due to downregulation)
-
Mechanisms for pathogen elimination
-
Induction of apoptosis, e.g., via the following enzymes:
- Granzyme: a serineprotease secreted by NK cells and cytotoxic T cells
- Perforin: a pore-forming protein secreted by NK cells and cytotoxic T cells
- Perforin forms a pore for granzyme B to enter the target cell
- Antibody-dependent cell-mediated cytotoxicity (activated by CD16-binding Fc region of bound IgG)
-
Induction of apoptosis, e.g., via the following enzymes:
-
NK cells are activated under the following conditions:
Thrombopoiesis (platelet production) [2]
- Location: bone marrow
- Duration: ∼ 1 week for production and maturation
-
Regulation: thrombopoietin
- Secreted by liver and kidneys
- Stimulates megakaryocyte proliferation and maturation in bone marrow (megakaryopoiesis)
- Stages of thrombopoiesis: myeloid precursor cell →megakaryoblasts →megakaryocytes →platelets
Platelet physiology
- Lifespan: 8–10 days
-
Concentration
- Reference range: 150,000–400,000/mm3
- The spleen stores about a third of the body's platelets, and these are not included in the platelet count.
- Abnormal platelet count: See “Thrombocytosis” and “Thrombocytopenia.”
- Function: primary hemostasis [30]
-
Platelet granules
- Dense granules: ADP, Ca2+, serotonin, histamine
- Alpha granules: vWF, fibrinogen, fibronectin, platelet factor 4